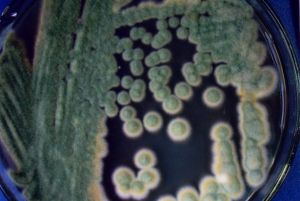
雜色麴黴原變種 雜色麴黴原變種

形態特徵
雜色麴黴原變種菌落在查氏瓊脂上生長局限,25℃7天直徑15-17mm,10-12天24-30mm;質地為絲絨狀或絮狀,或兩種質地並存或相互鑲嵌;菌落不平,稍厚,中央部分隆起或凹陷,或呈不同程度的翹曲;顏色差異很大,初為白色,後呈不同程度的綠色,近於青豆綠、阿福花綠(PoisGreen,asphodelGreen,R.XLI)至深葡萄綠(DeepGrapeGreen,R.XLI),有的菌株呈孔雀綠(malachiteGreen,R.XXXII),橄欖綠(OliveGreen,R.IV)或暗橄欖褐色(DarkOliveBuff,R.XL),間或有不呈綠色者,取決於分生孢子結構的多少;菌絲體呈黃褐色、粉紅色,近於淺褐粉紅色(BuffyPink.R.XXLIII)或淡粉紅肉桂色(Palepinkishcinnamrn,R.XXLX),因不同菌株而異;分生孢子結構有時形成遲緩;有輻射狀溝紋;滲出液有或無,近於無色或呈淡褐色至紫紅色,形成小滴或聚成大滴;無明顯氣味或稍具霉味;菌落反面顏色不一,自近於無色至淡黃褐色、粉紅色、玫瑰紫色或紫褐色,色素擴散於基質;有的菌株形成殼細胞,老培養物中可見聚成淡黃色的團塊。分生孢子頭較小,初為球形,後呈輻射形,直徑(25-)75-125μm;分生孢梗莖直接生自基質者(45-)150-300(-500)μm×4-8μm,生自氣生菌絲者大都很短,無色或稍帶黃色,壁較厚,光滑;頂囊半球形、稍長形或稍呈橢圓形,直徑9-20μm,約3/4的表面可育,小頂囊僅分生孢梗莖頂部稍加膨大而不明顯;產孢結構雙層:梗基一般5-8μm×2一3μm,瓶梗6-8μm×1.5-2.5μm;分生孢子球形或近球形,綠色,直徑(2-)2.5-3.5(-4)μm,壁粗糙,具小刺;殼細胞球形或近球形,直徑11-20μm,大量形成時聚成淡黃色的團塊。
菌落在查氏酵母膏瓊脂上25℃7天直徑18一22mm,10一14天27一30mm;質地絲絨狀至絮狀;邊緣白色或淺黃色;有的菌株中部氣生菌絲較多,呈厚絮狀;分生孢子結構呈不同程度的綠色,近於豌豆綠色、茶綠色、淡黃綠色(PeaGreen,TeaGreen,R·XLVII;pistachioGreen,R,xLI),具輻射狀鉤紋;菌落反面淡褐色至淡紅褐色。
菌落在麥芽汁瓊脂上25℃7天直徑15-17mm,10-12天24-30mm;較平;分生孢子結構較多,綠色,近於阿福花綠(AsphodeIGreen,R.XLI)或淺藜蘆綠(LightHelleloreGreen,R.XVII);反面無色或帶褐色。
生境
土壤、空氣、玉米、莜麥、腐爛水果、蔗渣、酒糟、藥材、樹皮、苔蘚、流脂、蠶體、板栗紅蚧、駝毛、飼料、酚醛塑膠、皮革、霉腐材料等。37℃不生長
中國分布
北京(MQ1846,MQ1847,MQ6669,MQ8002,MQ8023,MQ8024,MQ8403,MQ8623,MQ8676,MQ8909);河北張家口(MQ6683)、唐山(MQ8104)、小五台山(C68、C285,C433,C564,C586,C678,C1102);山西陽高(MQ8204);內蒙古呼和浩特(MQ5882)、包頭(MQ5890,MQ6382)、清水河(MQ6374)、察哈爾右中旗(MQ8067)、阿爾山(MQ4664,MQ4719,MQ4753);遼寧鐵嶺(MQ5695)、昌圖(MQ2817,MQ2818)、千山(MQ5796);黑龍江肇東(MQ2688);上海(MQ2737,MQ8316,MQ8317);江蘇南京(MQ5459,MQ5469,MQ5475)、啟東(MQ9);浙江杭州(MQ3365)、嘉興(MQ8508)、縉雲(MQ8402);安徽蕪湖(MQ8111)、黃山(MQ1918);福建福州(MQl0149)、三明(MQ8412);江西南昌(MQ5308);山東泰山(MQ5485,MQ5492));湖北巴東(MQ5545)、神農架(MQ6882,MQ6914,MQ7309,MQ9269);湖南衡陽(MQ5324,MQ5326)、邵陽(MQ2733);廣東廣州(MQ2799,MQ2801,MQ2806,MQ8081,MQ8096)、翁源(MQ2768,MQ2785)、江門(MQ2791,MQ2796);海南(MQ1174,MQ1812);四川成都(MQ5025)、貢嘎山(MQ6360)、青城山(MQ2103)、九寨溝(MQ2175,MQ2189,MQ9910);貴州務川(MQ8293);雲南昆明(MQ2072,MQ5083,MQ8118)、麗江(C4686)、大理(C5628)、下關(C5855)、芒市(C6468);西藏拉薩(MQ49)、安多(MQ1988)、定日(Cl716-2)、聶拉木(C1793)、吉隆(C1840,c2004),噶爾(MQ1986)、米林(MQ6710,MQ6715)、波密(MQ1728,MQ6330,MQ6742)、唐古拉山(MQI990)、珠穆朗瑪峰北坡(MQ996);陝西西安(MQ2001,MQ8800)、鹹陽(MQ4895)、渭南(MQ4892);甘肅蘭州(MQ5856,MQ6230)、武威(MQ5831);青海互助(MQ1977)、海北地區(MQ1983)、尖扎(MQI980);寧夏永寧(MQ5930)、中寧(MQ6457);新疆瑪納斯(MQ74)、托木爾峰(MQ4083);地點不詳(MQ2874,MQ6276,MQ8502,MQ8611)。
特點
土壤、空氣、酒麴、食品及各種材料(戴芳讕,1979);台灣台北、嘉義、台南;基物有土壤和貯存稻米(Tzeanetal.,1990)。
本種的模式材料未存,新模式產地不詳。分布廣泛,是世界性廣布種,也是我國最常見的麴黴之一。
雜色麴黴種的範圍很大,不同菌株在外觀上有很大差異,特別是顏色,正如學名所示,表現相當廣闊的變化而可能被認為是不同的種,但通過顯微鏡檢查可以看到其細微結構基本相同而察覺不到有多少差異,顯然是同一種,種內有些菌株有相當多的畸形;如小頂囊上只生有少數梗基和瓶梗,或不具梗基;有時瓶梗直接生於氣生菌絲上。
本菌能產生雜色麴黴素(sterigmatocystin),結構與黃麴黴毒素Bl相似,也是一種致癌物質,但毒性較低。我國分離的菌種中產毒株比例約為42.19%(賈珍珍等,1988)。本菌也是糧食含水量超過16%時的最普通的"貯藏真菌"(storagefungi)之一(Kozakiewicz,1989)。
盤點麴黴屬及其相關有性型的真菌
| 麴黴屬是叢梗孢目(Moniliales)叢梗孢科中的一屬。在自然界分布極廣,是引起多種物質霉腐的主要微生物之一。本期主要是盤點該屬及其相關。 |